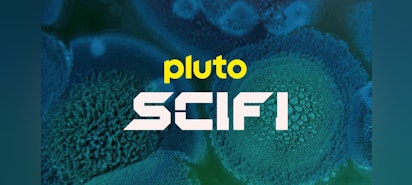

how do you search for a show on pluto tv app
Make sure your Smart TV is connected to the same Wi-Fi network as your Android PhoneTablet or. Take free TV with you anywhere when you download the free Pluto TV app on your phone or tablet.
Virgin Media Adds Pluto Tv App Virgin Media
Watch 250 channels of free TV and 1000s of on-demand movies and TV shows.
. Chromecast - Mobile and Web. Visit the Roku channel store using your TV. Select Pluto TV from the list of options.
The leading free streaming TV and movie service is available to you. Join us and become a cordcutter today. Watch 100s of live TV channels and 1000s of movies and TV shows all streaming free.
Another way to search Pluto TV is by looking through the channels list guide. The leading free streaming TV and movie service is available to you. Its worth noting that the process for.
To favorite a channel follow these steps. Find Great Deals on Tech at Amazon - httpamznto2q35kbcPluto TV How To See Guide on Pluto TV App Step by Step Instructions Guide TutorialIn this video. You can only look ahead 2-3 hours on any channel in their guide.
Click on the Get or Download option. Watch 100s of live tv channels and 1000s of movies and tv shows all streaming free. Watch 100s of live TV channels and 1000s of movies and TV shows all streaming free.
Log into your Roku account. Pluto is awesome but limited. Display the playback controls at the bottom of the screen.
You can watch Pluto TV online with a mobile app for Android and iOS and on. Basic How To Information. Turn onoff apple airplay mirroring.
Pluto TV - Drop in. Install the Pluto TV iPhoneiPad app or Android PhoneTablet app. To delete Pluto TV from your iPhone Follow these steps.
Apple TV Roku Amazon Fire TV and Android TV devices all have apps available as well plus smart TVs from Vizio Samsung and Sony offer up a Pluto TV app. Get help with your Smart TV Roku Fire TV Apple TV. We offer advice on live streaming and on demand services antennas and OTA DVRs.
Dont miss 247 CSI the latest news from CNN live sports and more anytime and. This will give you a quick overview of all the live and on-demand channels on Pluto TV. Pluto TV also offers.
Then youll see several types of streaming apps as a search result. Would love a search feature but there isnt one. If by any chance you have Roku you can use it to add Pluto TV to your smart TV.
They change things from time to time. Find Out The Pluto Tv App From The Search Result. Extended Guide.
How to update Password or Email. On your homescreen Tap and hold Pluto TV - Live TV and Movies until it starts shaking. Once it starts to shake youll see an X.
Pluto TV is a top free streaming service with over 43 million monthly active users globally. Select Live TV and start watching the channel you want to favorite. Find Great Deals on Tech at Amazon - httpamznto2q35kbcPluto TV How To Search - How To Search on Pluto TV App Step by Step Instructions Guide TutorialI.
Under that label select Search and type Pluto TV. Pluto tv you can search for shows on pluto tv by browsing the. You can scroll down.
Find the app named Pluto Tv- Live Tv and Movies. How to View More Info about a Program in a Browser.
Pluto Tv It S Free Tv Tv App Roku Channel Store Roku
How To Watch Pluto Tv In Canada Step By Step
How To Watch Pluto Tv In Canada Easily April 2022
How To Watch Pluto Tv Outside The Us With A Vpn In 2022
Pluto Tv Channel List 2022 Full Channel Guide Techcrachi Com
Pluto Tv App Channels Guide And How To Activate Tom S Guide
Pluto Tv Reviews 202 Reviews Of Pluto Tv Sitejabber
Download Pluto Tv For Ios Free 5 17
How To Search For Shows On Pluto Tv On Any Platform
Pluto Tv Everything You Need To Know About The Free Tv Streaming Service Techradar
How To Search On Pluto Tv 4 Ways
How To Search For Shows On Pluto Tv On Any Platform
How To Search On Pluto Tv Easy Guide Robot Powered Home
How To Search On Pluto Tv Easy Guide Robot Powered Home
How To Search For Shows On Pluto Tv On Any Platform
Pluto Tv Reorganizes Channels As Lineup Expands Fierce Video
Pluto Tv How To Search How To Search On Pluto Tv App Instructions Guide Tutorial Youtube